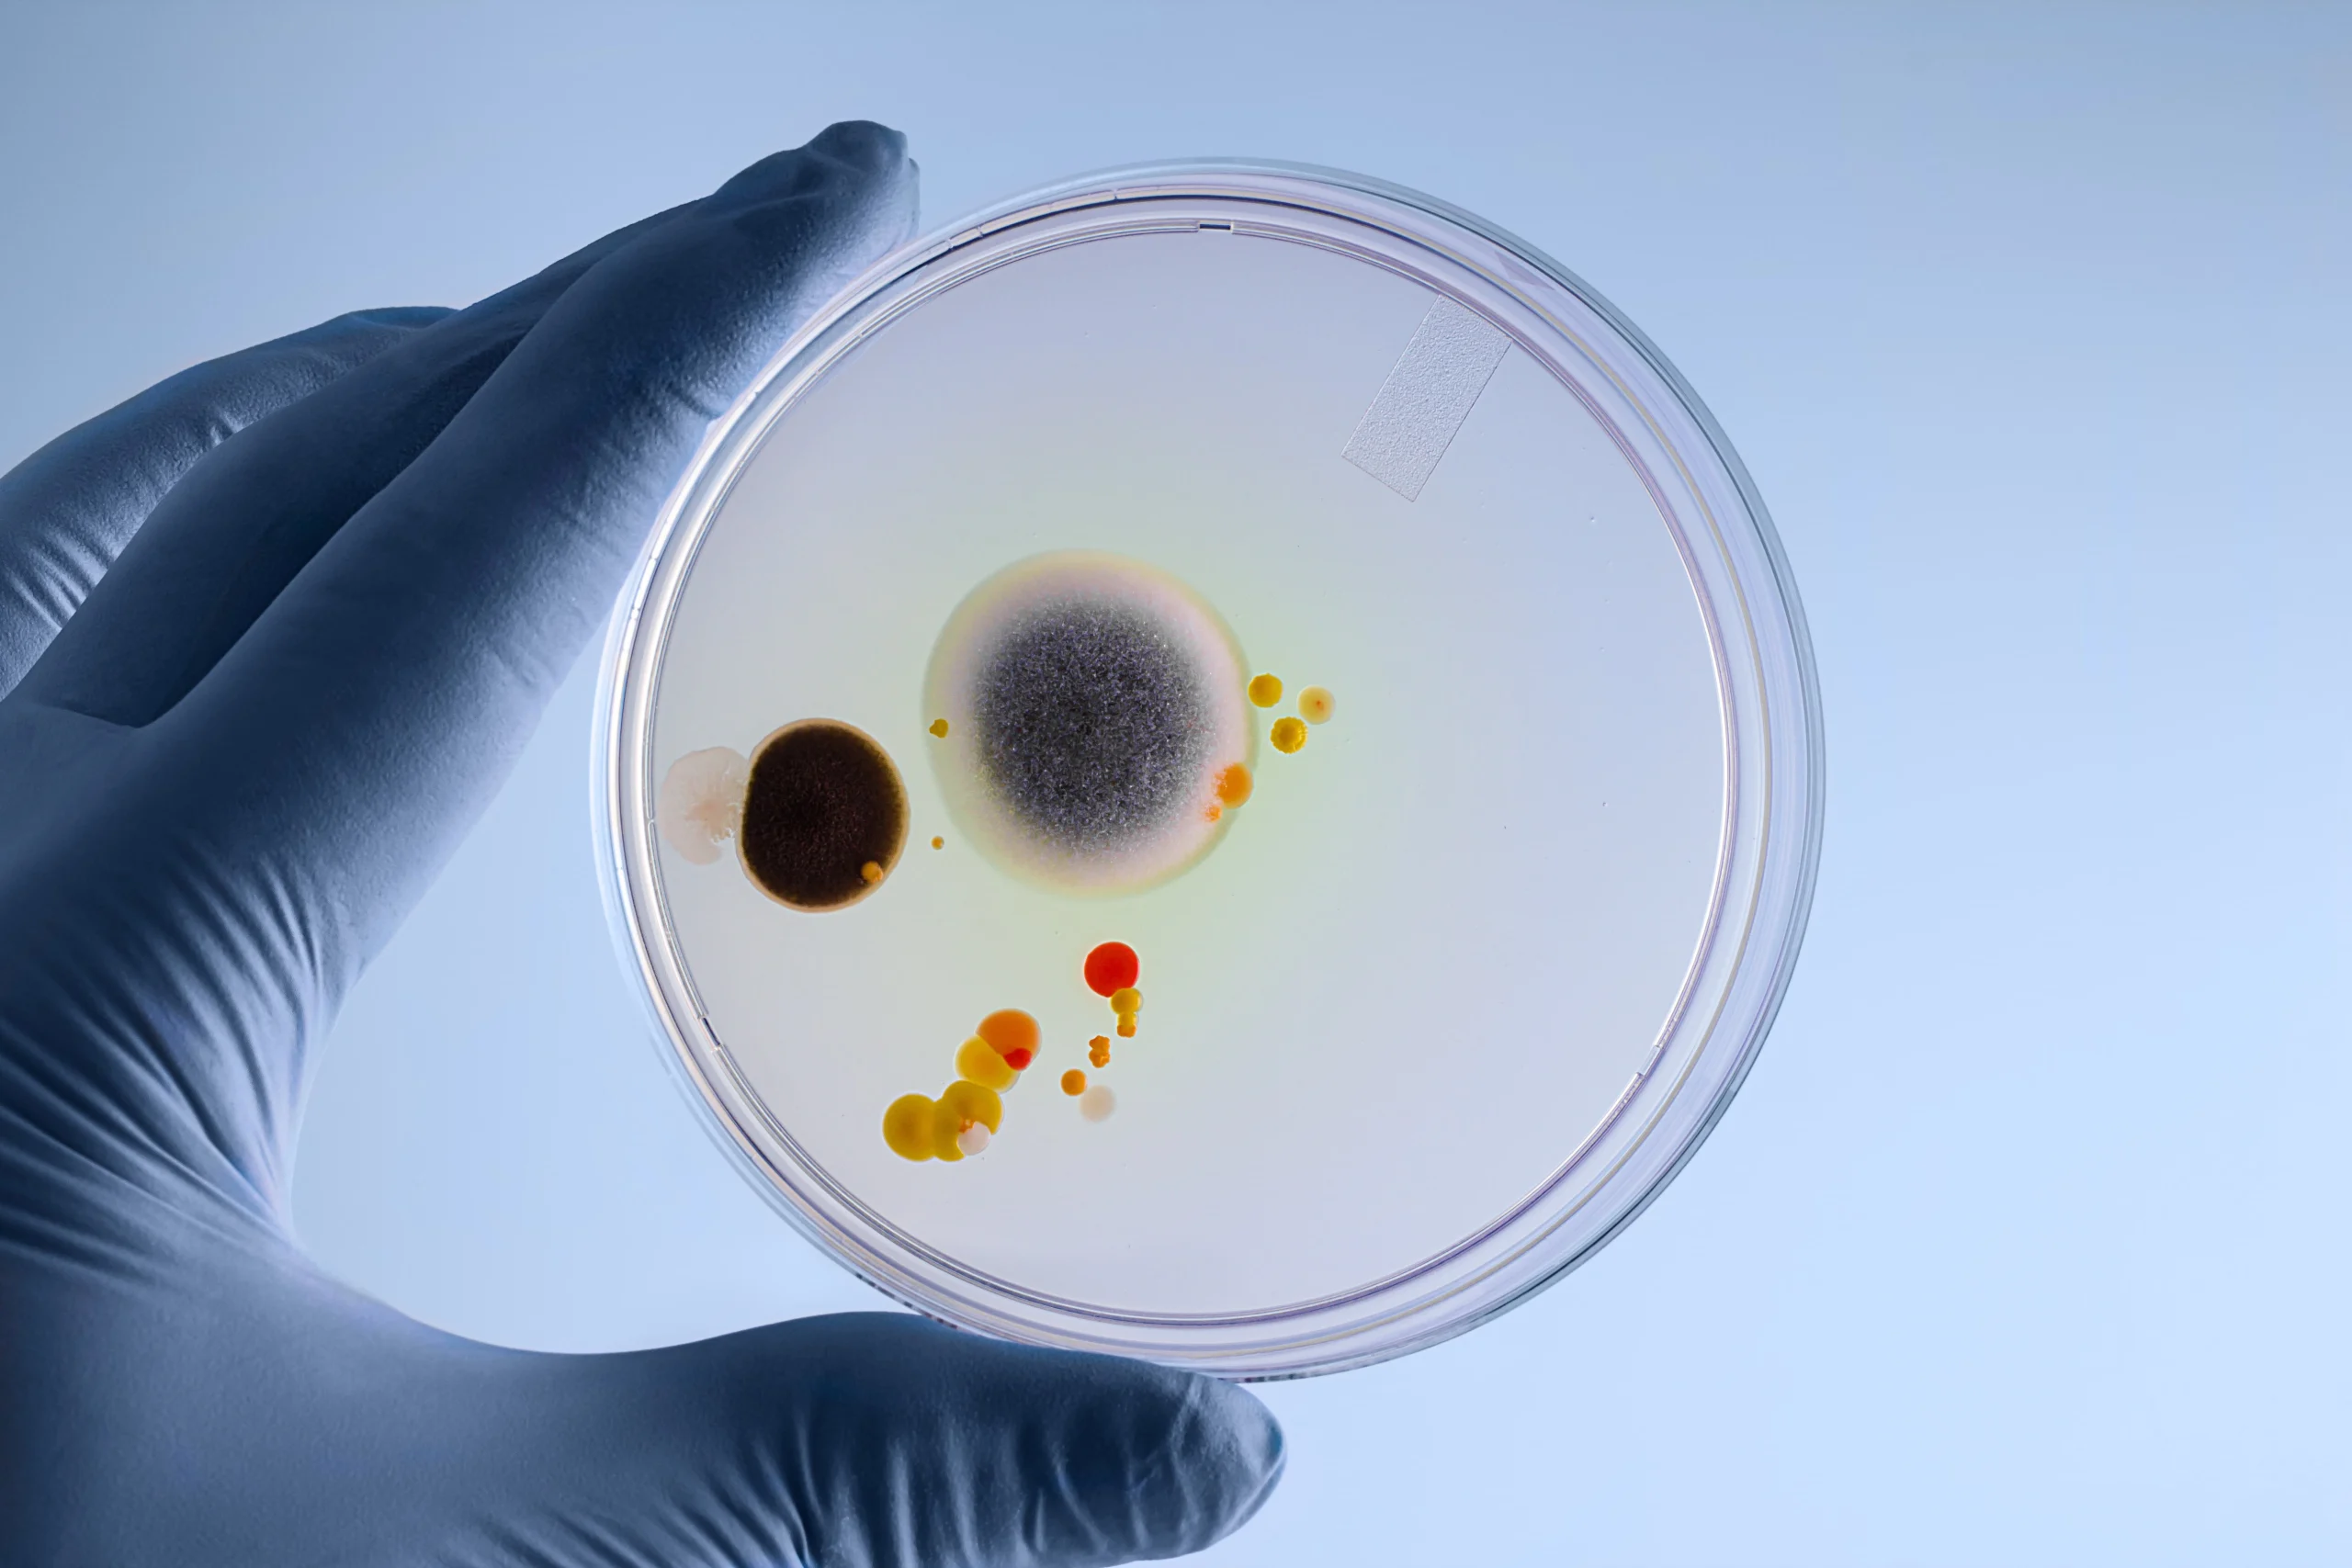

ClearHome Bio Testing
Protecting Homes, Safeguarding Health
Biotoxin Testing for Northern Colorado
Uncover Hidden Dangers in Your Home
At ClearHome Bio Testing, we specialize in detecting biotoxins that may be affecting your health and your home’s safety. Whether you are experiencing unexplained health issues or want to ensure a property is free from mold and endotoxins before purchasing, we are here to provide accurate, science-based testing solutions. Our mission is to bring awareness to the dangers of biotoxins and to help families stay safe in their homes.
Why Choose ClearHome Bio Testing?
Many companies rely on outdated air testing methods that do not provide a full picture of mold contamination. Our advanced dust testing techniques reveal the true biotoxin load inside your home.
Our journey is personal—we have experienced firsthand the devastating effects of undetected mold and endotoxins. This firsthand experience showed us that there is a critical need for more comprehensive and accurate testing solutions. Up to 25% of people are genetically susceptible to severe reactions, and our goal is to prevent others from suffering the same fate.
ClearHome Service Menu
Mold Testing
Sewer Smoke Test
Endotoxin Dust Sampling
Our Service Area
We proudly serve Northern Colorado, covering a 60-mile radius from Denver. If you’re within our service area and need reliable biotoxin testing, we are here to help.
Schedule Your Biotoxin Testing Today!
Don’t let hidden mold, endotoxins, or sewer leaks compromise your health. Contact ClearHome Bio Testing today for professional, accurate testing solutions that give you peace of mind.
- Weekend appointments available
- Quick Turnaround
- Online Payments Accepted